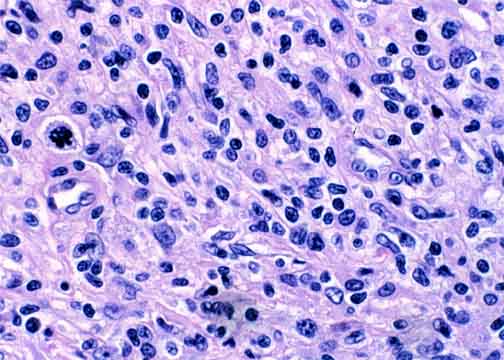

Go to:

TOC
|
Peripheral T-Cell Lymphomas: Example 2B
This is a subsequent biopsy from the same patient as Example 2A. Note how the lymphoma has progressed to a more aggressive morphology, both architecturally and cytologically.

The atypical T-cell infiltrate involves the entire dermis and (though not
seen here) the superficial subcutis. The epidermis is spared, with a
pale, uninvolved Grenz zone in the immediately subjacent dermis. |
A mixture of small and large atypical cells is present. Notice how
the lymphoma has progressed from the earlier specimen
(Example 2A). The infiltrate is
much denser and the cells larger and more atypical. The nuclei of the larger
cells are twisted or convoluted rather than oval or cleaved as
would be seen in most B-cell lymphomas. |

Table of Contents 
|



